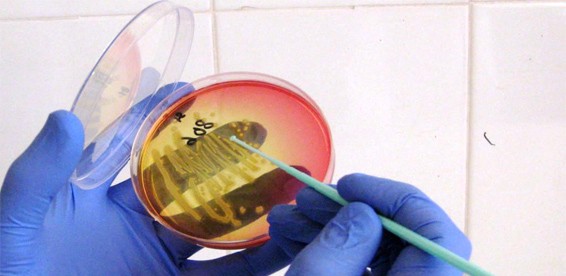
#

Скидка 63% На программы медицинского обследования для мужчин в медицинском центре «Гинмед».
-
5Уже купили
купонов
- Описание акции
- Вопросы и ответы
- Отзывы (0)
-
Комплексные программы медицинского обследования для мужчин в медицинском центре «Гинмед»:
Скидка 63% на программу №1: купон 540 руб. + доплата на месте 850 руб. (вместо 3 800 руб.)
Скидка 66% на программу №2: купон 690 руб. + доплата на месте 1 100 руб. (вместо 5 200 руб.)
Программа №1:
• первичная консультация, прием и осмотр у врача-уролога
• ТРУЗИ предстательной железы (трансректальное)
• мазок на 4 инфекции (гонорея, трихомонады, кандида, гарднерелла)
• исследование на Лептотрикс (Leptothrix), Mobiluncus, Lactobacillus sp (грам+кокки, грам-кокки, грам+диплококки, грам-диплококки, коккобациллярная флора, грам+палочки, грам-палочки)
• клинический анализ крови (24 показателя)
• забор анализов крови
• выдача результатов обследования на руки
Программа №2:
• первичная консультация, прием и осмотр у врача-уролога
• ТРУЗИ предстательной железы (трансректальное)
• мазок на 4 инфекции (гонорея, трихомонады, кандида, гарднерелла)
исследование на Лептотрикс (Leptothrix), Mobiluncus, Lactobacillus sp (грам+кокки, грам-кокки, грам+диплококки, грам-диплококки, коккобациллярная флора, грам+палочки, грам-палочки)
• ПЦР-диагностика на 4 инфекции (хламидия, микоплазма, уреаплазма уреалитикум, уреаплазма парвум)
• анализ крови на рак предстательной железы (ПСА)
• клинический анализ крови (24 показателя)
• забор анализов крови
• выдача результатов обследования на руки
Один человек может использовать один купон по данной акции и только один раз.
Информацию по условиям акции вы также можете уточнить по телефонам компании:
+7 (495) 232-55-92, +7 (495) 452-48-61
Вы можете купить неограниченное количество купонов для себя и в подарок.
Каждым купоном можно воспользоваться только один раз.
Необходима предварительная запись по телефону с указанием номера купона.
Предъявляйте распечатанный купон на месте.
Если вы не предупреждаете об отмене своего визита за 12 часов до времени записи, купон считается использованным.
При опоздании более чем на 15 минут или в случае полной загруженности клиника оставляет за собой право перенести процедуру на любое другое удобное вам и клинике время.
Скидка по купону не суммируется с другими действующими предложениями клиники.
Купон необходимо оплатить в течение 24 часов с момента заказа.Купон действует с 1 ноября по 1 января 2018 года.Описание акции
«Гинмед» - центр качественного медицинского сервиса, в котором прием ведут врачи высшей категории и кандидаты медицинских наук с огромным опытом работы в ведущих медицинских центрах Москвы. В центре работают не просто врачи высокой квалификации, а специалисты, которым присущи такие важные черты, как отзывчивость и чуткость, стремление к совершенствованию, умение внимательно выслушать и понять проблему пациента.Здесь царит домашняя, уютная и комфортная атмосфера. Весь персонал - высококвалифицированный, добрый и отзывчивый. Администратор ответит на все вопросы и при необходимости подключит врача.
В центре работают не просто врачи высокой квалификации, а специалисты, которым присущи такие важные черты, как отзывчивость и чуткость, стремление к совершенствованию, умение внимательно выслушать и понять проблему пациента.Здесь царит домашняя, уютная и комфортная атмосфера. Весь персонал - высококвалифицированный, добрый и отзывчивый. Администратор ответит на все вопросы и при необходимости подключит врача.Адрес: г. Москва Головинское шоссе,д.8,корп 3. м. Водный стадион Телефон: +7 (495) 452-48-61, 8-916-124-18-27 Время работы: с 9-30 до 21-00 Адрес сайта: http://www.ginmed.ru/ Артикул акции: 99167 Схема проезда:

Вернем деньги

Вернем разницу

Вернем деньги

Вернем 10%